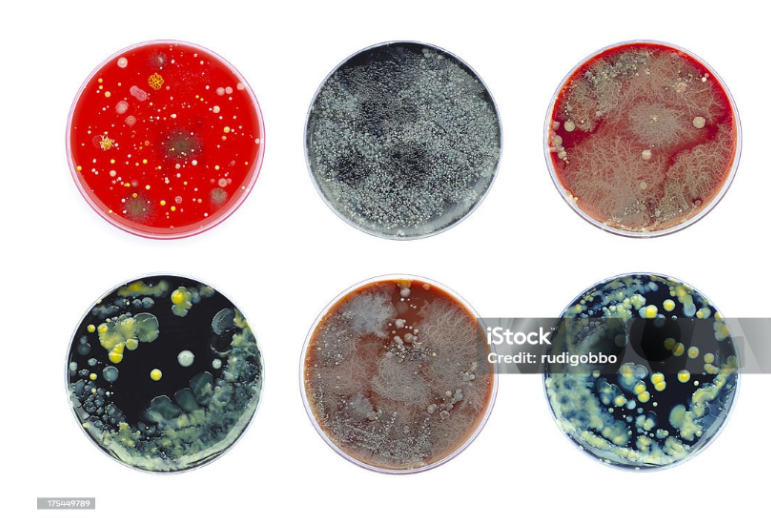

Fongs
Fongs, Hongos, Fungi
Pertany al camp de aparell i sistema del cos humà.
Definició:
Català: Són un grup de microorganisme pluricel·lulars o unicel·lulars eucariotes (amb nucli), que inclouen les floridures, els llevat i els bolets.
Castellà: Son un grupo de microorganismo pluricelulares o unicelulares eucariotas (con núcleo), que incluyen las mohos, las levaduras y las setas.
Informació complementària: Alguns fongs poden causar malalties a la pell, com les tinyes, i altres manifesten la seva presència sobre matèria orgànica per la formació de filaments cel·lulars que arriben a formar masses cotonoses. Es desenvolupen amb facilitat en ambients humits.